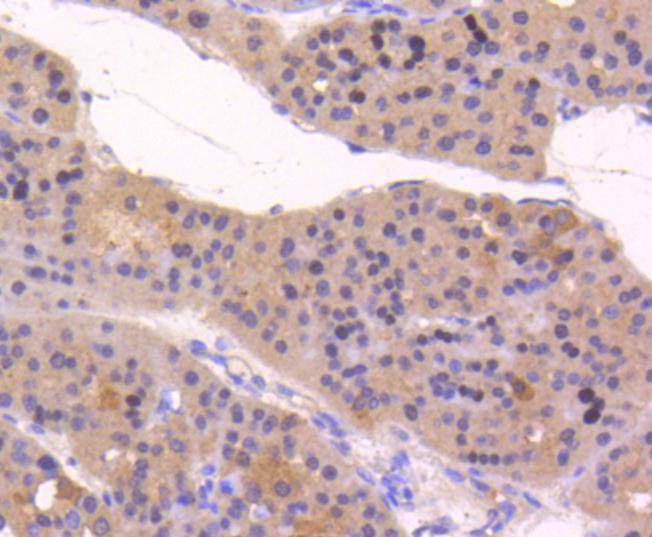
verifiedActivity

购物车
 您的购物车当前为空
您的购物车当前为空
Anti-ATF-5 Antibody (6Y194) 是一种 Rabbit 抗体,靶向 ATF-5。Anti-ATF-5 Antibody (6Y194) 可用于 ICC/IF,IHC,IP,WB。
Anti-ATF-5 Antibody (6Y194) 是一种 Rabbit 抗体,靶向 ATF-5。Anti-ATF-5 Antibody (6Y194) 可用于 ICC/IF,IHC,IP,WB。
| 规格 | 价格 | 库存 | 数量 |
|---|---|---|---|
| 50 μL | ¥ 1,490 | 5日内发货 | |
| 100 μL | ¥ 2,485 | 5日内发货 |
TargetMol的所有产品仅用作科学研究或药证申报,不能被用于人体,我们不向个人提供产品和服务。请您遵守承诺用途,不得违反法律法规规定用于任何其他用途。
| 产品描述 | Anti-ATF-5 Antibody (6Y194) is a Rabbit antibody targeting ATF-5. Anti-ATF-5 Antibody (6Y194) can be used in ICC/IF,IHC,IP,WB. |
| Ig Type | IgG |
| 克隆号 | 6Y194 |
| 反应种属 | Human,Mouse,Rat |
| 验证活性 | 1. Western blot analysis of ATF5 on different lysates using anti-ATF5 antibody at 1/1,000 dilution. Positive control: Lane 1: Jurkat, Lane 2: PC-12. 2. Immunohistochemical analysis of paraffin-embedded human tonsil tissue using anti-ATF5 antibody. Counter stained with hematoxylin. 3. Immunohistochemical analysis of paraffin-embedded human liver cancer tissue using anti-ATF5 antibody. Counter stained with hematoxylin. 4. Immunohistochemical analysis of paraffin-embedded mouse stomach tissue using anti-ATF5 antibody. Counter stained with hematoxylin. 5. Immunohistochemical analysis of paraffin-embedded mouse heart tissue using anti-ATF5 antibody. Counter stained with hematoxylin. 6. ICC staining ATF5 in Hela cells (green). The nuclear counter stain is DAPI (blue). Cells were fixed in paraformaldehyde, permeabilised with 0.25% Triton X100/PBS. 7. ICC staining ATF5 in PC-12 cells (green). The nuclear counter stain is DAPI (blue). Cells were fixed in paraformaldehyde, permeabilised with 0.25% Triton X100/PBS. |
| 应用 | ICC/IFIHCIPWB |
| 推荐剂量 | WB: 1:1000-2000; IHC: 1:50-200; ICC/IF: 1:50-200 |
| 抗体种类 | Monoclonal |
| 宿主来源 | Rabbit |
| 构建方式 | Recombinant Antibody |
| 纯化方式 | ProA affinity purified |
| 性状 | Liquid |
| 缓冲液 | 1*TBS (pH7.4), 1%BSA, 40%Glycerol. Preservative: 0.05% Sodium Azide. |
| 研究背景 | Eukaryotic gene transcription is regulated by sequence-specific transcription factors that bind modular cis acting promoter and enhancer elements. The ATF/CREB transcription factor family binds the palindromic cAMP response element (CRE) octanucleotide TGACGTCA. The best characterized members of this gene family include CREB-1, CREB-2 (also designated ATF-4), CRE-BPa, LZIP (also designated CREB3 and Luman), CREM-1, CREM-2, ATF-1, ATF-2, ATF-3, ATF-5, ATF-6 and ATF-7. This family of proteins contain highly divergent N-terminal domains, but share a C-terminal leucine zipper for dimerization and DNA binding. ATF-5 (ATFx), which can localize to the cytoplasm or the nucleus, binds DNA as a dimer. It interacts with CCND3 and PTP4A1. |
| 偶联 | Unconjugated |
| 免疫原 | Recombinant Protein |
| Uniprot ID |
| 分子量 | Theoretical: 31 kDa. |
| 储存方式 | Store at -20°C or -80°C for 12 months. Avoid repeated freeze-thaw cycles. |
| 运输方式 | Shipping with blue ice. |